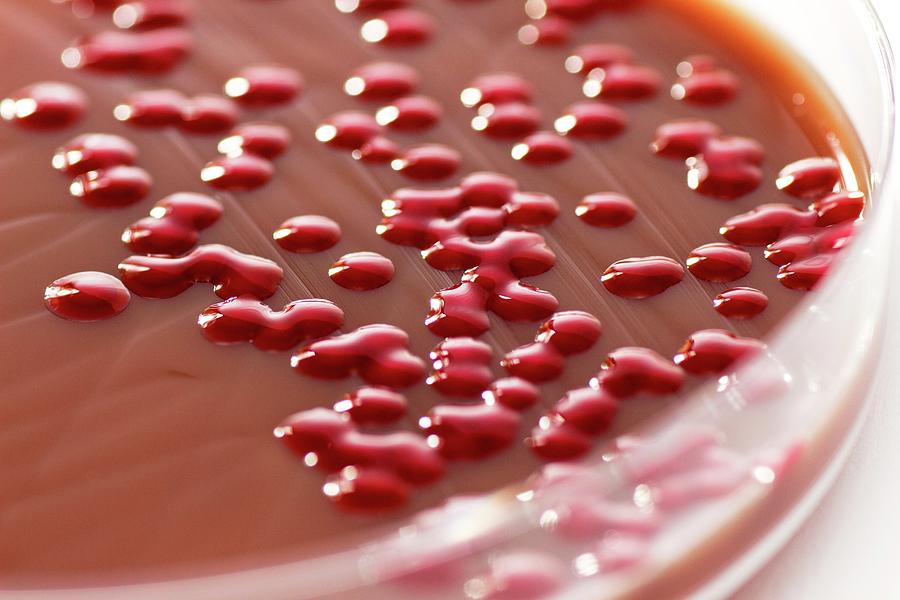

Ο θαυμαστοβάκιλος, γνωστός και ως Serratia marcescens, είναι ένα βακτήριο που συνήθως εμφανίζεται ως μια ροζ ή κοκκινωπή λάσπη σε υγρές περιοχές όπως τα μπάνια. Αν και γενικά θεωρείται ακίνδυνο για τους υγιείς ανθρώπους, ενδέχεται να αποτελέσει απειλή για όσους έχουν εξασθενημένο ανοσοποιητικό σύστημα.
Κίνδυνοι για την υγεία:
Λοιμώξεις: Σε σπάνιες περιπτώσεις, μπορεί να προκαλέσει λοιμώξεις του ουροποιητικού και του αναπνευστικού συστήματος, καθώς και άλλα προβλήματα υγείας.
Ευπαθείς ομάδες: Επίσης άτομα με εξασθενημένο ανοσοποιητικό σύστημα, όπως οι ηλικιωμένοι, τα βρέφη και τα άτομα με χρόνιες παθήσεις, είναι πιο ευάλωτα στις επιπτώσεις του.
Τι πρέπει να κάνετε:
Ωστόσο εάν παρατηρήσετε ροζ λάσπη στο μπάνιο σας, είναι σημαντικό να δράσετε άμεσα για να την απομακρύνετε και να αποτρέψετε την επανεμφάνισή της.
Επιβεβαίωση: Επιπλέον βεβαιωθείτε ότι πρόκειται για Serratia marcescens. Η ροζ ή κοκκινωπή απόχρωση είναι χαρακτηριστική.
Καθαρισμός: Καθαρίστε σχολαστικά τις προσβεβλημένες περιοχές με μια βούρτσα για να απομακρύνετε τη λάσπη και τα υπολείμματα.
Απολυμαντικά: Χρησιμοποιήστε καθαριστικά με βάση τη χλωρίνη ή άλλα απολυμαντικά με αντιμικροβιακές ιδιότητες.
Αερισμός: Βελτιώστε τον αερισμό του μπάνιου για να μειώσετε την υγρασία, η οποία ευνοεί την ανάπτυξη του βακτηρίου.
Πρόληψη: Καθαρίζετε τακτικά τις επιφάνειες, τις κουρτίνες του ντους και τα πλακάκια, και ξεπλένετε καλά τα υπολείμματα σαπουνιού και σαμπουάν.
Σημαντικά σημεία:
Η υγιεινή είναι απαραίτητη για την πρόληψη της ανάπτυξης του βακτηρίου.
Επίσης η έγκαιρη αντιμετώπιση του προβλήματος ελαχιστοποιεί τους κινδύνους για την υγεία.
Η γνώση είναι δύναμη, με την σωστή ενημέρωση είμαστε σε θέση να προστατέψουμε την υγεία μας.
Χορηγούμενο